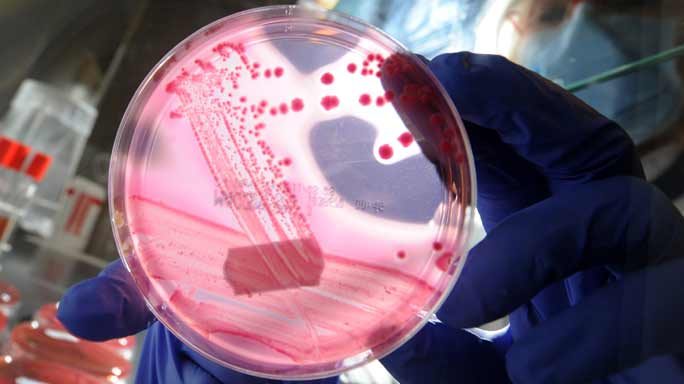

Health officials are warning about a “particularly concerning” antibiotic-resistant superbug they believe has been responsible for two deaths in Victoria in the last three years.
Hospitals have been advised to strictly enforce current standards on managing antibiotic-resistant bacteria and new interim guidelines have been put in place, particularly for patients who have recently received medical treatment overseas.
The new bug is a strain of CRE (carbapenem-resistant enterobacteriaceae) known as KPC and is resistant to some of the most powerful antibiotics.
• ‘Superbugs’ rife in Australian nursing homes
• Medieval potion could be used to kill super bug
• Superbugs could herald an ‘end to modern medicine’
Fifty-seven people have been infected or colonised by the bacteria in Victoria since 2012, the majority of which were in a cluster at St Vincent’s Hospital.
Eighteen of those affected have died and health officials believe KPC was responsible for at least two of those deaths, Dr Finn Romanes, the state’s acting chief health officer said.
“It would be likely that quite a number of patients will have died because of, or through contribution from this infection. That’s why we’re taking this problem seriously,” he said.
“We’re advising now that our system is on heightened alert.
“We are determined to do all we can to prevent, detect and manage this problem.”
No new cases since March

So far this year three elderly patients have become infected with KPC at St Vincent’s Hospital but there have been no new cases since March.
The bacteria can be present in a patient’s bowels without causing any problem but some may develop a urinary tract or blood stream infection.
Dr Romanes said hospitals have been urged to introduce new interim screening requirements to pick up the bacteria, which is typically found in Greece and Italy.
“We are taking significant action to protect public health by asking all hospitals to introduce heightened infection control and prevention measures, to ensure these highly antibiotic-resistant bacteria are not spread,” Dr Romanes said.
“All Victorian health services have been provided with information from the Department of Health and Human Services emphasising the need to ensure all current national standards [on managing antibiotic-resistant bacteria] are in place and being strictly followed.”
International literature showed the mortality rate for those with a bloodstream infection can be 30 to 50 per cent.
Associate Professor Kumar Visvanathan from St Vincent’s Hospital said KPC had a “difficult pattern of spread and potentially a long incubation period” which is why it is so difficult to control.